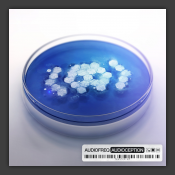
Audioception

filter

Out of Nowhere
Blugazer feat. Catherine

The Castle Of Nowhere (Pumpkin Anthem 2013)
Mindblast & Aleave

Dance The Night Away
Modana feat. Tay Edwards

Lieder
Adel Tawil

Everybody Go Up & Down
Dang Nguyen

New Beginning / Metal Play / The Nameless
The Beast Project

Ade 2K13 - The Compilation
Various Artists

Beautiful World Of Fantasy
Maximilian Blach & Rafaele Castiglione

How I Roll
Darius & Finlay & TK Tycoon

Breakaway
Weaver & Impact

Wistfulness
Wasted Penguinz

Wistfulness
Wasted Penguinz

W.A.R.
B-Front & Re-Volt

Walls Come Down/Uh Oh!
John Dahlbäck

Lullaby For Two
Denis Kenzo feat. Sveta B.
Audioception
Audiofreq

Cosmic Sin / Bring It To Them Raw (Feat. Sasha F) / The Illusion (Feat. Dark Pact)
Warface

Take Me Away
Stu Infinity

Go Down
Dyro

Two Shots For The Crowd (Homicidal Gang 05)
The Braindrillerz
✘
Von:
Interpret:
Track:
Nachricht: